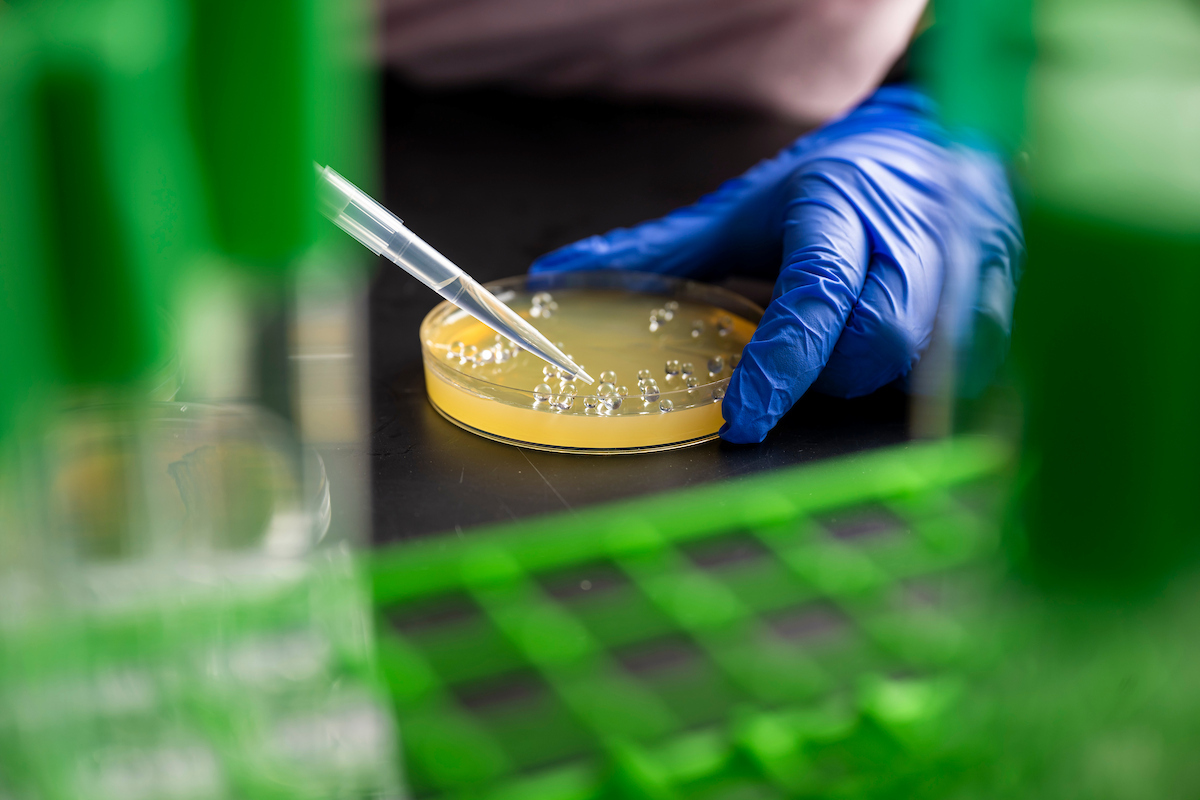

Overview
The Founding Director is charged with building and leading successful interdisciplinary teams of faculty, technical and administrative staff, and industry, government and non-profit partners with a focus on developing emerging technologies toward biotech and biomedical applications. Partnerships with industry stakeholders (e.g., industrial research consortia and NSF IUCRC program) will be particularly important to the success of the Director in service to the Kummer Institute's broader goals of enhancing economic development.
The Director will develop a transformational vision for the center that leverages existing campus resources and faculty strengths, while identifying opportunities to lead Missouri S&T toward international prominence in bio-innovation and medical engineering. The Founding Director will hold a faculty appointment at the rank of professor within a department at Missouri S&T that aligns with his/her area(s) of expertise, although the primary focus of this position will be leading and facilitating major multidisciplinary research proposals, especially with industry, and the administrative duties of center leadership.
Successful applicants for the Founding Director position will:
- Be recognized as an international leading researcher in one or more disciplines from biological and medical informatics, biomaterials, bioprocessing/biomanufacturing, drug delivery, biosensors and instrumentation, neurobiology, biomedical engineering, biochemical engineering and related fields.
- Possess the technical expertise and prior accomplishments necessary to make Missouri S&T a global leader in bioinnovation and medical engineering.
- Demonstrate prior evidence of research excellence and establishing a vision, building relationships with industry partners, and establishing coalitions of university and/or government stakeholders to work toward strategic goals, especially major external grants and contracts, in complex, changing environments.
- Build inclusive teams that foster professional development and mentorship, facilitate cooperation and teamwork, and support constructive resolution.
- Hold an unwavering commitment to student success through exceptional research, mentorship, instruction, and career placement activities.